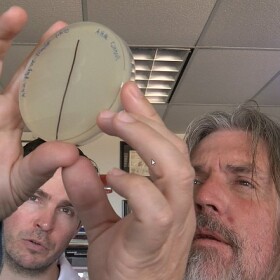

Hippocrates said, “Let food be thy medicine and medicine thy food.”
Researchers from San Diego State University took that ancient wisdom and doubled down, unlocking new insight into how specific foods can customize the bacteria in our guts and ultimately our health.
The target is bacteriophage, or phage for short. They are viruses that live inside the bacteria that live inside of our gut, constantly influencing our state of health and disease.
In a laboratory at SDSU, phage art is displayed as paintings, drawings, and sculptures. Phage look like top-heavy tripods with long tails, used to insert themselves into bacteria cells where they can replicate until the cells burst open.
“There's about 10 times as many phage in our body than there are human cells,” said Lance Boling, a molecular biologist and research associate at San Diego State University. “We cultivate them since the moment that we're born. And we have them all the way until we're dead. And they're ... they're just kind of part of life.”
He is part of a team experimenting with the idea that feeding these phage common, everyday foods could change the landscape of our gut microbiome, in what he calls gut sculpting.
“And it's really popular these days to improve the health of your gut microbiota. And by understanding the effect that these foods are having on our gut microbiota, we can kind of affect our own health in positive ways,” Boling said.
RELATED: ‘Cultured’: A Look At How Foods Can Help The Microbes Inside Us Thrive
Forest Rowher is a microbial ecologist and biology professor at SDSU who spearheaded the study. He talks about how phages work on bacterial cells.
“So these viruses live inside the cells. And every once in a while they get activated, which we call induction, and they jump out and they blow up the cells," he said. "So, the idea of this study was, could we control when they jump out? And so can we get them to kill a specific set of bacteria?”
To test this hypothesis, the researchers harvested phages from a sewage treatment plant. They then began growing the phage in Petri dishes, systematically feeding them 117 different foods, rumored to have microbial properties, such as honey, neem, oregano, and garlic.
The scientists measure their success by holding up the Petri dishes to daylight streaming in from large windows in the lab. With this method they can see a clearing, indicating where the phages have killed a specific species of bacteria. The cloudy areas are where the bacteria are still growing abundantly.
“Do they blow up or not? That's about it. It's, it's really easy,” Rowher said.
What is most remarkable, is the ability to kill certain bacteria without affecting other, beneficial bacteria. The researchers believe this could mean the potential for more gentle options to kill bacteria without annihilating the entire microbiome, as some antibiotics can do.
“Because they’re so broad-spectrum, they can kill the microbes in your gut that are so necessary for our health," Boling said. "So you might get rid of an infection that is causing one condition and opening yourself up for all of these other conditions.”
“So, we want things that will kill this bacteria but not that bacteria,” Rowher said. "But even better, we'd like to be able to adjust some of these different types of bacteria. So you may not want to kill all of a particular bacteria, but you might kill most of them off. So these things would hopefully be able to do that.”

They found honey, stevia, neem oil, uva ursi, and aspartame to have the most impact on the phage. They also tested toothpaste.
“I was curious with the toothpaste to see if maybe you were inadvertently causing some effects on our microbiome," Boling said. "We think you just kind of brush your teeth and spit it out. But maybe some of that residual antimicrobials that are in the toothpaste are affecting our gut microbiota in ways that we're unaware of.”
Toothpaste did have a strong effect.
“A lot of the foods are surprisingly powerful antimicrobials and we just don't even realize it,” Boling said.